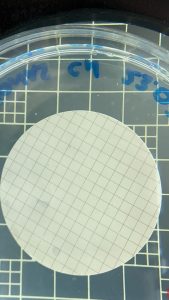

La questione dello “Pseudomonas Aeruginosa”, sembra essere destinata a risolversi. Una faccenda che ha tenuto Mastella col fiato sospeso e con lui parte della popolazione del Rione Libertà. Il batterio non è più presente nell’acqua prelevata alla fontana pubblica di via Piccinato a Benevento, fa sapere Gesesa. Quanto rilevato nei giorni scorsi, è stato un episodio puntuale e sporadico e non di tipo strutturale, sostengono da Pezzapiana, i risultati delle analisi effettuate confermano la buona qualità dell’acqua da sempre distribuita e garantita a tutti gli utenti e che la stessa è sicura da utilizzare per il consumo umano. Mastella attende i risultati delle analisi effettuate dall’ASL per revocare l’ordinanza n° 89835 e mettere fine alla vicenda. Vicenda che però lascia aperta la porta a parecchi interrogativi. Perchè, per esempio non è stata interrotta l’erogazione idrica in presenza della non potabilità accertata e se è vero, come afferma Altrabenevento, che della cosa Asl e Arpac sapessero dal 15 settembre, martedi, e avessero informato il Comune chiedendo lo stop all’erogazione, cosa non avvenuta. Italo Di Dio proporrà una interrogazione per capire come sono andate realmente le cose
La questione dello “Pseudomonas Aeruginosa”, sembra essere destinata a risolversi. Una faccenda che ha tenuto Mastella col fiato sospeso e con lui parte della popolazione del Rione Libertà. Il batterio non è più presente nell’acqua prelevata alla fontana pubblica di via Piccinato a Benevento, fa sapere Gesesa. Quanto rilevato nei giorni scorsi, è stato un episodio puntuale e sporadico e non di tipo strutturale, sostengono da Pezzapiana, i risultati delle analisi effettuate confermano la buona qualità dell’acqua da sempre distribuita e garantita a tutti gli utenti e che la stessa è sicura da utilizzare per il consumo umano. Mastella attende i risultati delle analisi effettuate dall’ASL per revocare l’ordinanza n° 89835 e mettere fine alla vicenda. Vicenda che però lascia aperta la porta a parecchi interrogativi. Perchè, per esempio non è stata interrotta l’erogazione idrica in presenza della non potabilità accertata e se è vero, come afferma Altrabenevento, che della cosa Asl e Arpac sapessero dal 15 settembre, martedi, e avessero informato il Comune chiedendo lo stop all’erogazione, cosa non avvenuta. Italo Di Dio proporrà una interrogazione per capire come sono andate realmente le cose
Per l’Amministrazione parla l’assessore all’Ambiente Giorgione
Segue servizii